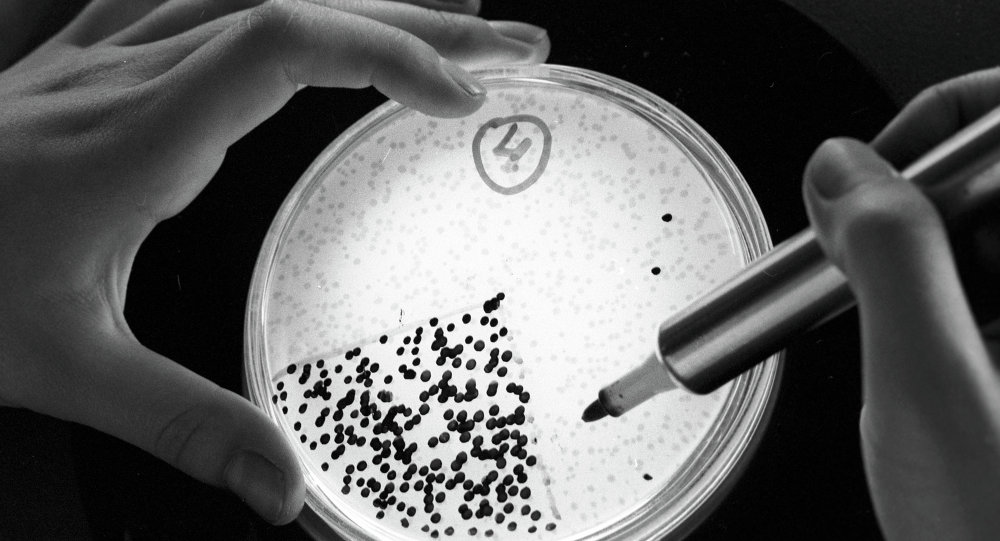

آخر المواضيع المضافة

|
أقرأ أيضاً
التاريخ: 20-2-2020
التاريخ: 22-2-2016
التاريخ: 18-2-2016
التاريخ: 2025-02-10
التاريخ: 27-12-2017
|













